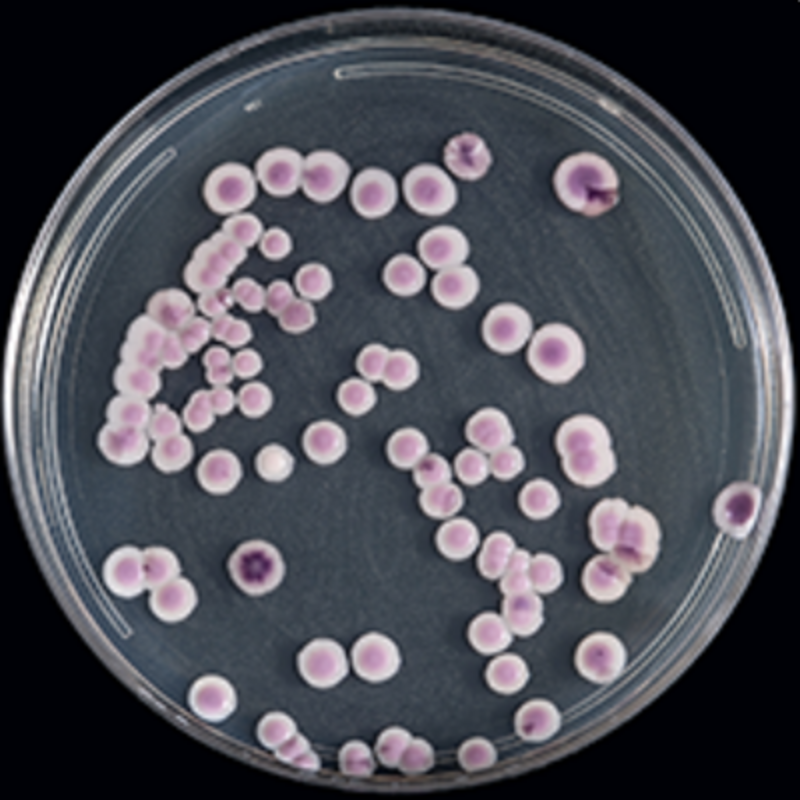
Как Candida auris стала серьезной глобальной угрозой

После первого японского пациента в 2009 году C. auris за последующие 4-5 лет распространилась по всему миру.
Клиницисты быстро обратили внимание на высокий уровень резистентности этого нового вида к противогрибковым препаратам, особенно к классу азолов, и кажущуюся легкость распространения. Быстрое распространение этого патогена, безусловно, стало тревожной тенденцией.
Что делает Candida auris такой значимой?
Она обладает высокой лекарственной резистентностью, и это еще мягко сказано. Пожалуй, лучше всего это видно при сравнении со вторым по лекарственной резистентности видом Candida, Candida glabrata. Уровень резистентности среди изолятов C. auris к флуконазолу, препарату класса азолов, составляет около 90%, по сравнению с 11% для C. glabrata, что особенно тревожно, если учесть, что флуконазол-резистентная Candida входит в число наиболее серьезных угроз, связанных с резистентностью к антибиотикам.
Для амфотерицина В уровень резистентности среди изолятов C. auris составляет около 30%, что может показаться сравнительно небольшим... пока вы не знаете, что для C. glabrata он составляет <1%. Что еще хуже, этиология резистентности C. auris еще не изучена, хотя предполагается, что причиной является чрезмерное использование противогрибковых препаратов. К счастью, большинство изолятов C. auris остаются чувствительны к противогрибковым препаратам класса эхинокандинов.
Она легко распространяется. Это связано с высокой скоростью передачи от человека к человеку и непрямой передачей через контаминацию. Она может колонизировать кожу человека, сохраняться на твердых поверхностях в течение нескольких недель и устойчива к уничтожению многими распространенными дезинфицирующими средствами. Неудивительно, что она представляет большой риск вспышек в медицинских учреждениях, где есть скопление пациентов, инфицированных поверхностей и людей с ослабленным иммунитетом.
C. auris часто ошибочно диагностируется как Candida haemulonii, Candida famata, Candida lusitaniae или Rhodotorula glutinis с помощью методов биохимического тестирования, включая автоматизированные системы идентификации, такие как VITEK 2, BD Phoenix и MicroScan WalkAway, а также тест-системы API для ручной идентификации. Такое сочетание факторов вызывает серьезную тревогу как исследователей, так и клиницистов и пациентов.
Как идентифицируют Candida auris?
Конечно раньше будет выявлен возбудитель инфекции и определена его чувствительность, тем быстрее можно начать соответствующую терапию. И неоднократно было доказано, что существует прямая зависимость между временем начала целенаправленной терапии и выживаемостью пациента. Это особенно верно для патогенов с высокой лекарственной резистентностью. Как же лаборатории выявляют C. auris?
В отличие от Candida guilliermondii, C. lusitaniae и Candida parapsilosis, которые часто ошибочно определяются бак.анализаторами, C. auris не образует гифы или псевдогифы на агаре с кукурузной мукой. В отличие от большинства видов Candida, за исключением C. parapsilosis, C. auris будет расти в условиях высокой концентрации соли (10% NaCl) и при высокой температуре (40-42˚C). Хромагары позволяют дифференцировать виды Candida, при этом C. auris проявляется в виде белых, красных, розовых или фиолетовых колоний. Однако ни один из этих методов, используемых отдельно, не идентифицирует C. auris. Единственными достоверными методами являются:
- матрично-ассистированная лазерная десорбция/ионизационная времяпролетная масс-спектрометрия (MALDI-TOF MS);
- и секвенирование D1-D2 области 28S или внутренней транскрибируемой области (ITS) рДНК с помощью ПЦР в реальном времени.
Как лечится Candida auris?
Как и при лечении других инвазивных инфекций Candida, для начальной терапии рекомендуется использовать эхинокандины (каспофунгин, анидулафунгин и микафунгин). Это особенно целесообразно, поскольку эхинокандины являются единственным препаратом, сохраняющим высокую активность в отношении C. auris. Переход на амфотерицин В (полиен), а затем на флуконазол рекомендуется, если пациент не реагирует на терапию или у изолята обнаружена резистентность к эхинокандинам. Несомненно нельзя забывать о строгих мерах профилактики и контроля инфекций для предотвращения передачи C. auris, поскольку она может колонизировать нестерильные участки тела и затем стать инвазивной или распространиться среди других людей.
К таким мерам относятся:
- Меры предосторожности при контакте с инфицированными или колонизированными пациентами, включая помещение в палату одного пациента.
- Гигиена рук, особенно для медицинских работников.
- Дезинфекция оборудования и помещений соответствующими дезинфицирующими средствами.
- Скрининг близких контактов и лиц, входящих в группу риска. К последней группе относятся лица, инфицированные или колонизированные грамотрицательными бактериями, резистентными к карбапенемам.
География C. auris постоянно меняется по мере ее распространения по всему миру: мы постоянно узнаем о ней что-то новое и совершенствуем наши меры борьбы с ней. В процессе своего распространения она успела привлечь интерес общественности, вызывая у одних больше тревоги, чем у других. C. auris продолжает оставаться интересным организмом для изучения и опасным патогеном в медицинских учреждениях.
Дисклеймер: оригинал данной статьи опубликован в 2019 г., поэтому, возможно, некоторые указанные в статье данные, требуют корректировки с учетом сегодняшних реалий.